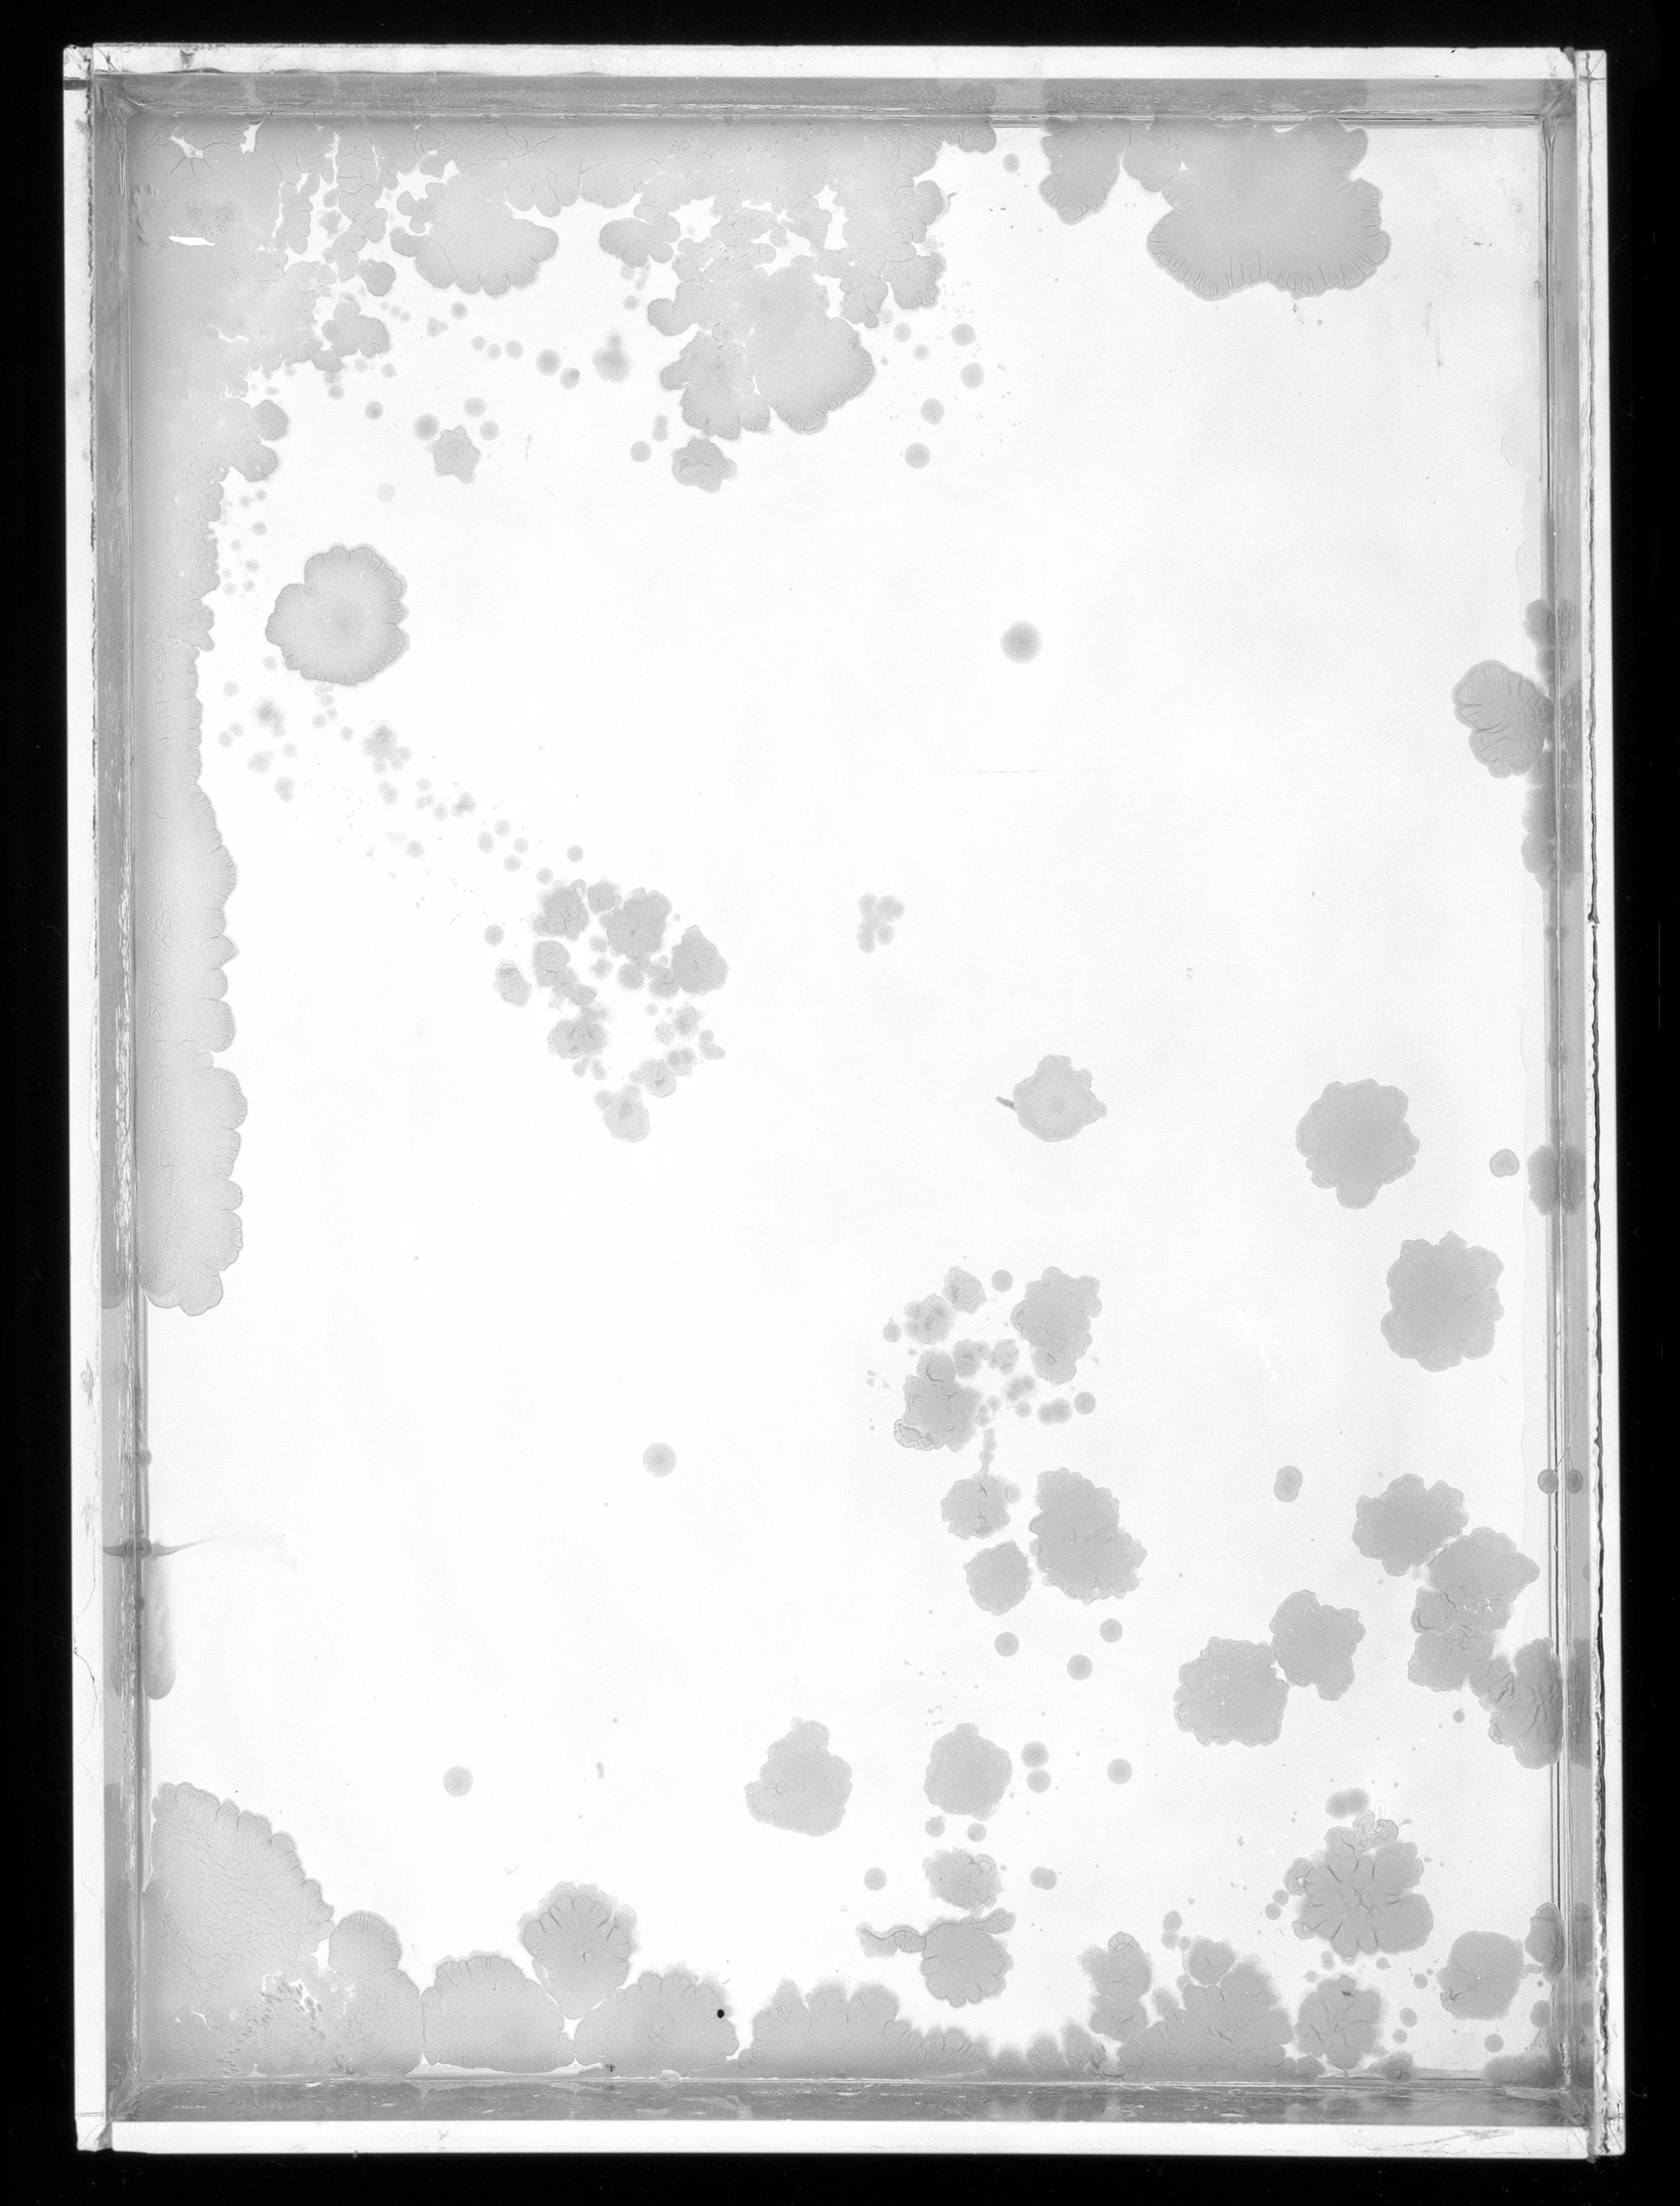
2023_Plates_4B_8x.jpg
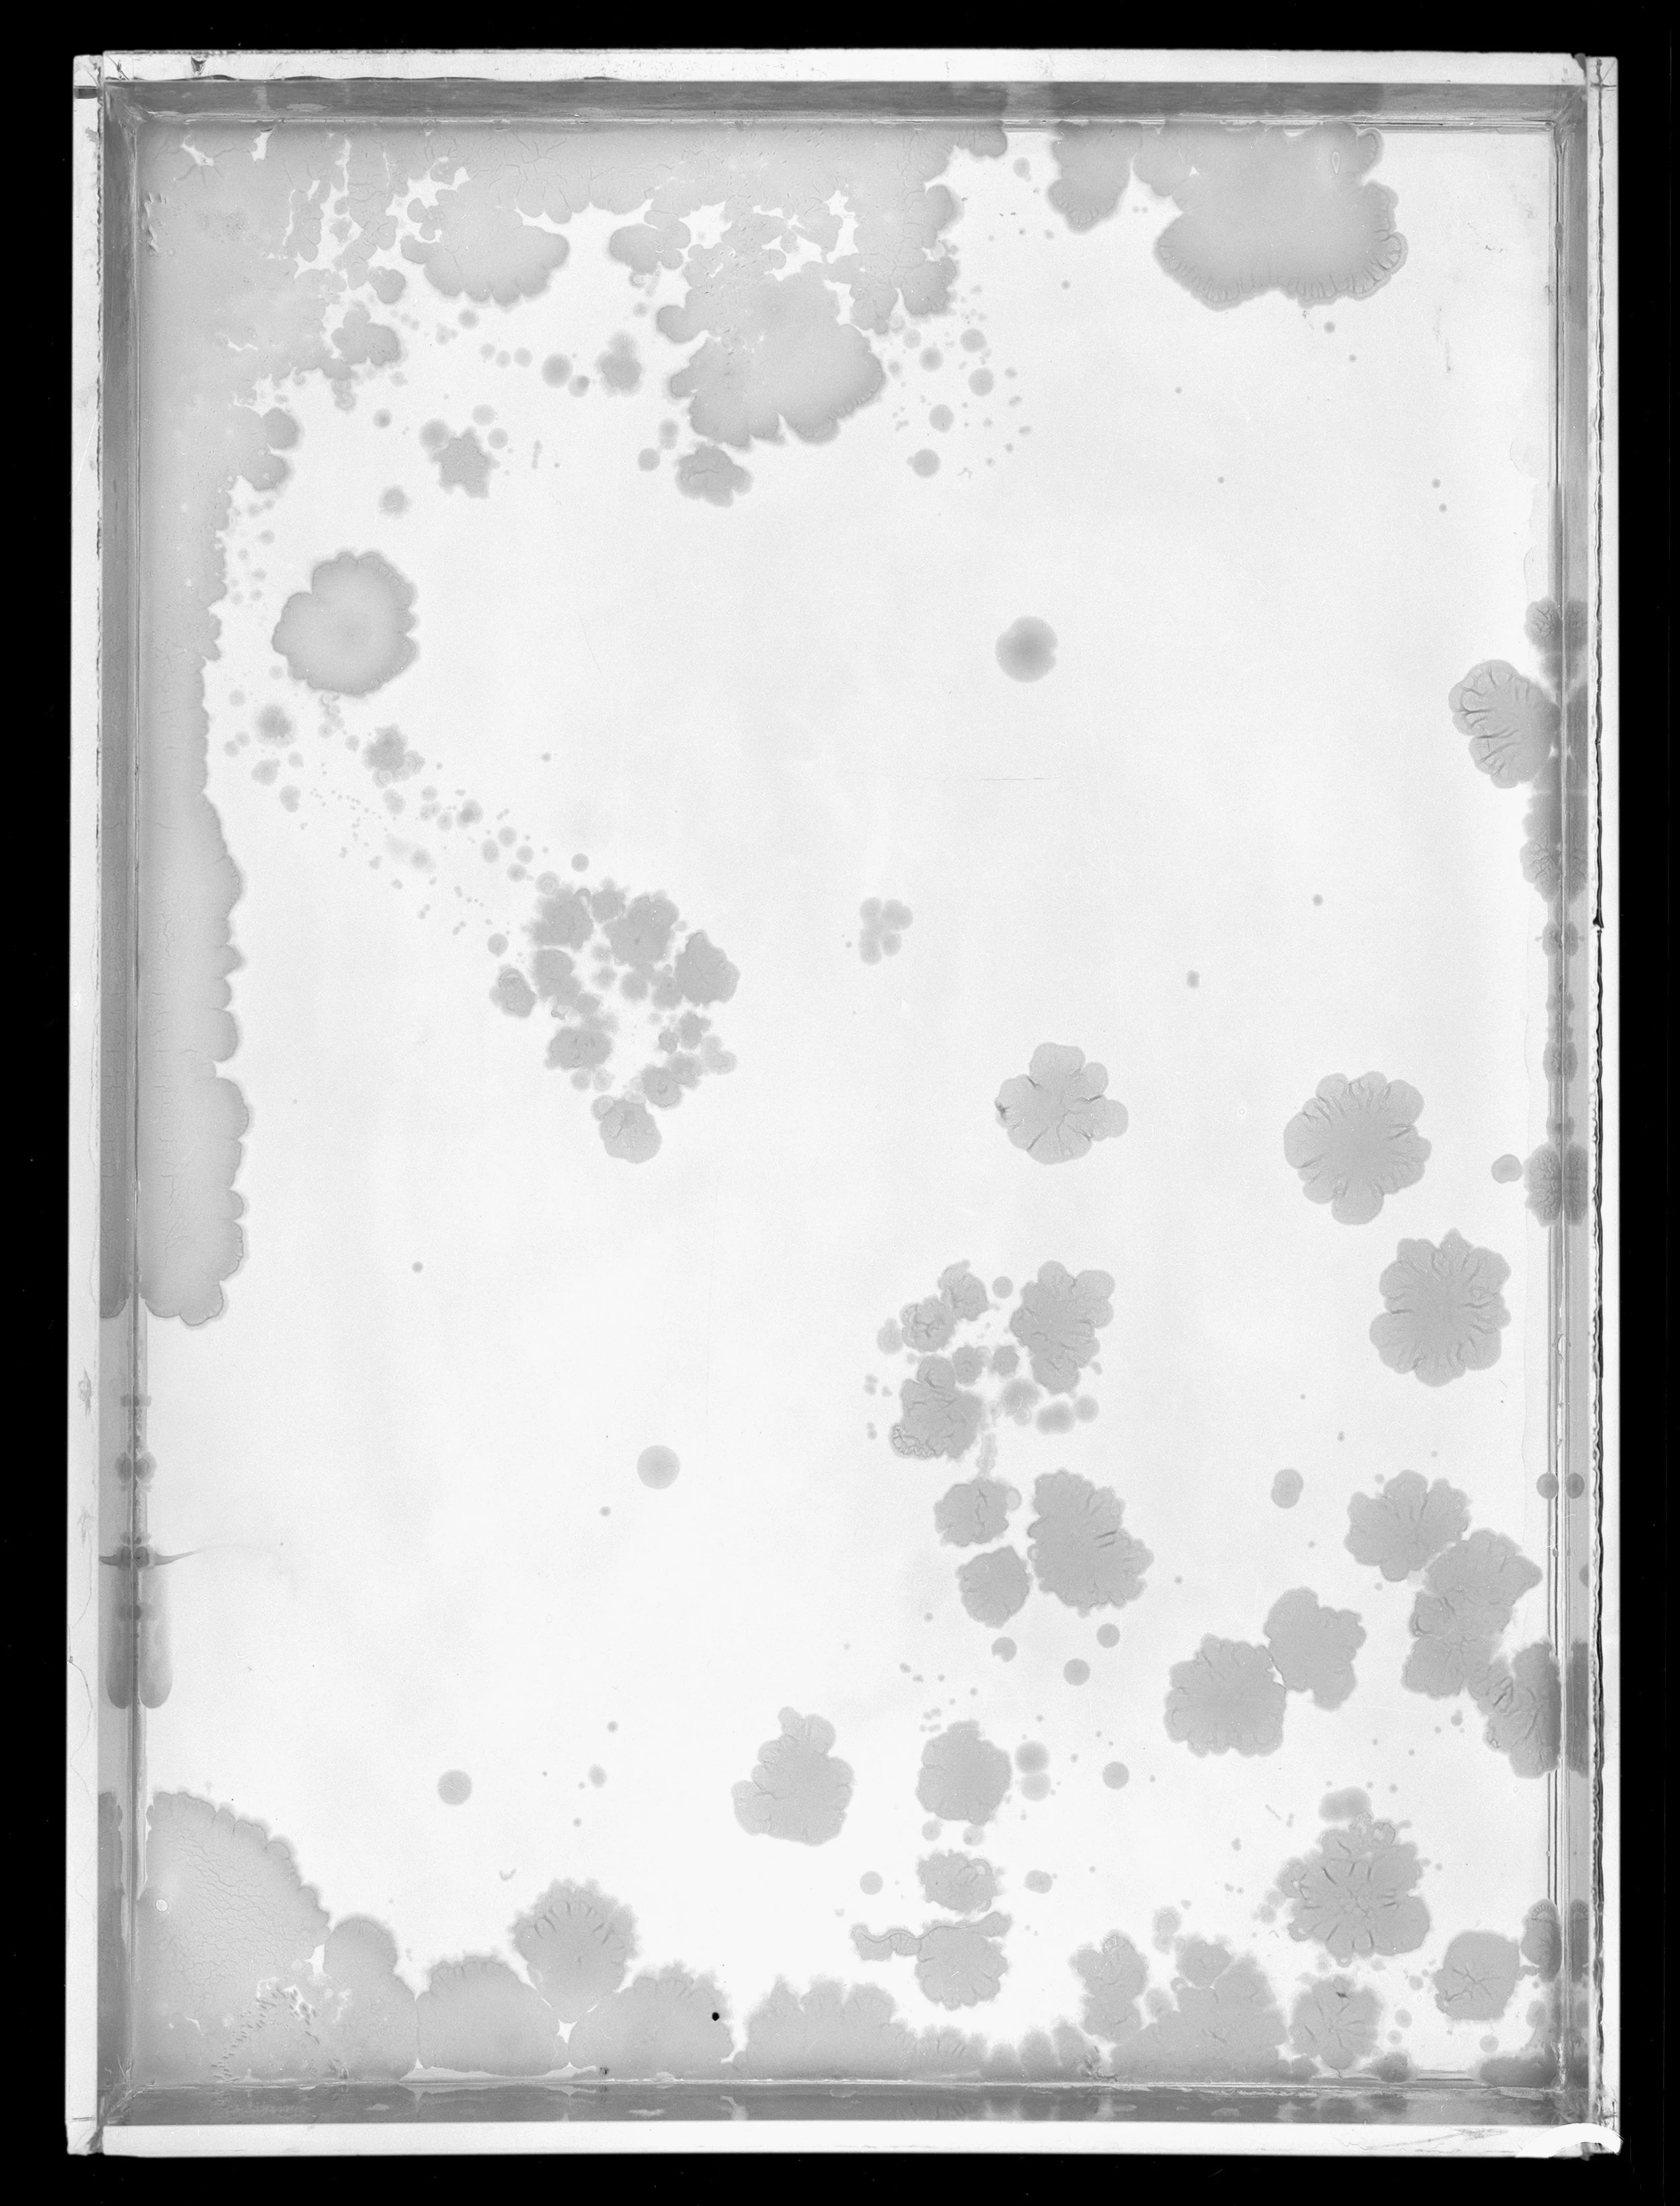
2023_Plates_5A_8x.jpg
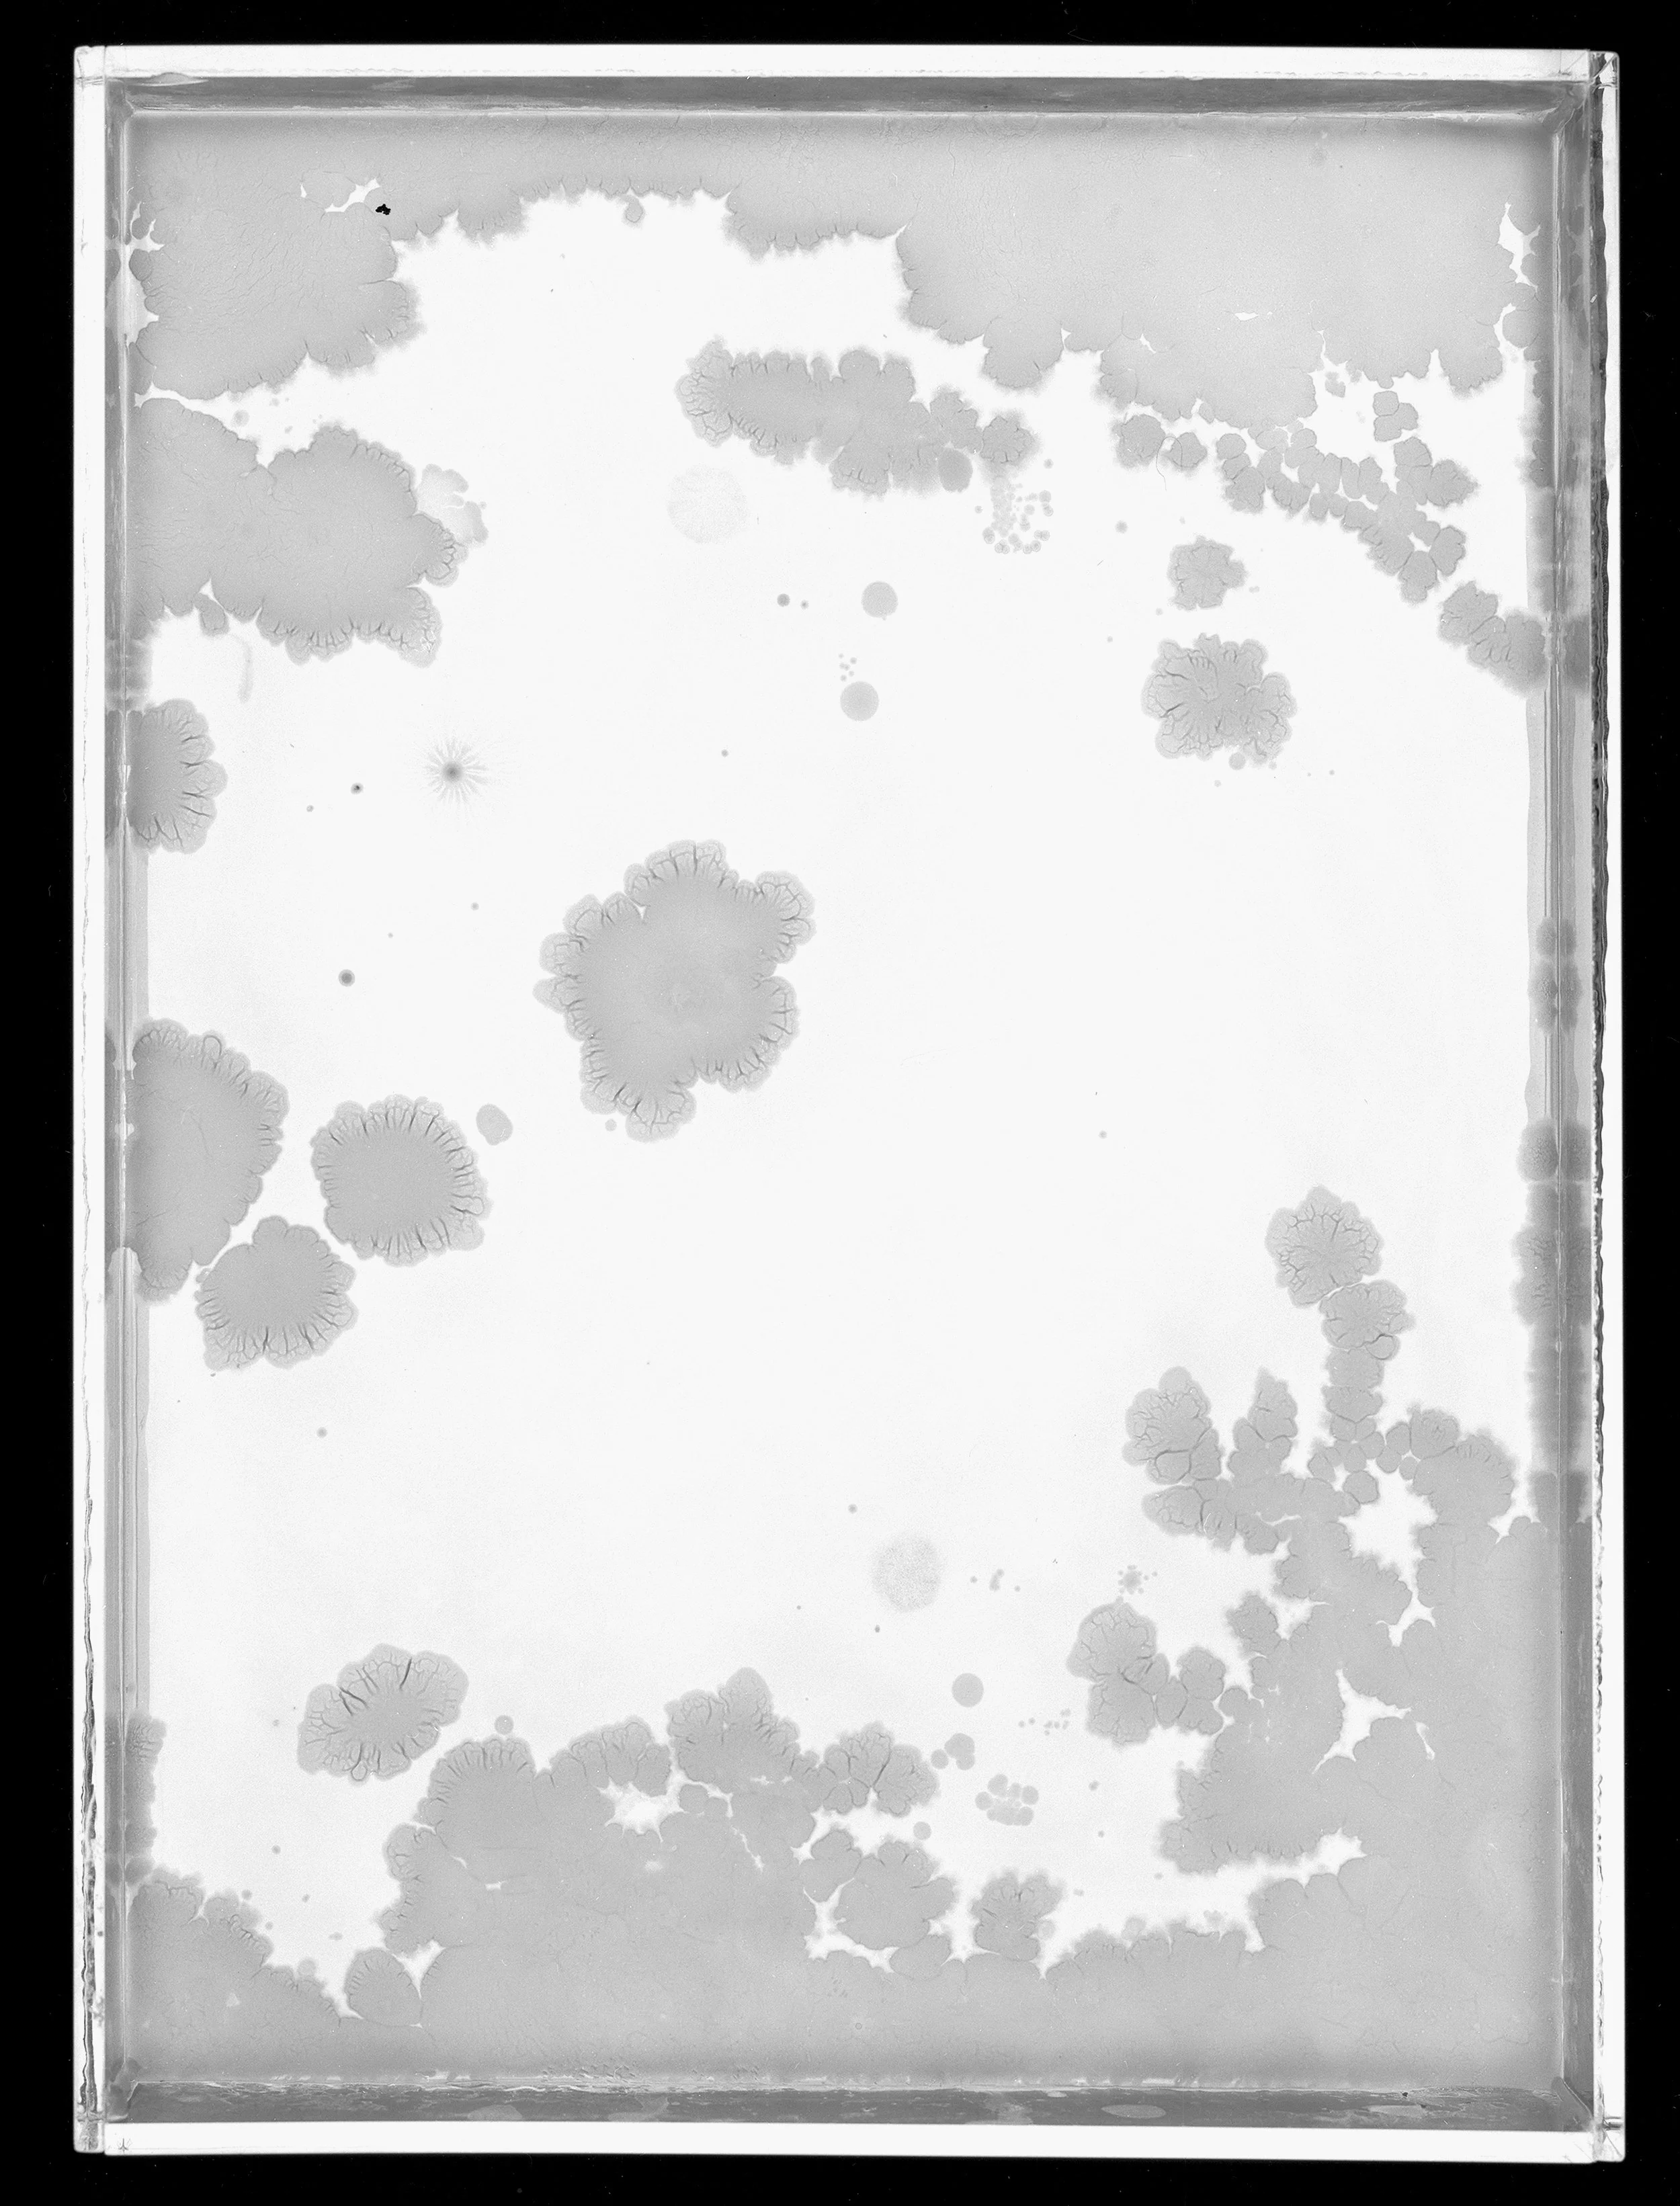
2023_Plates_6B_8x.jpg
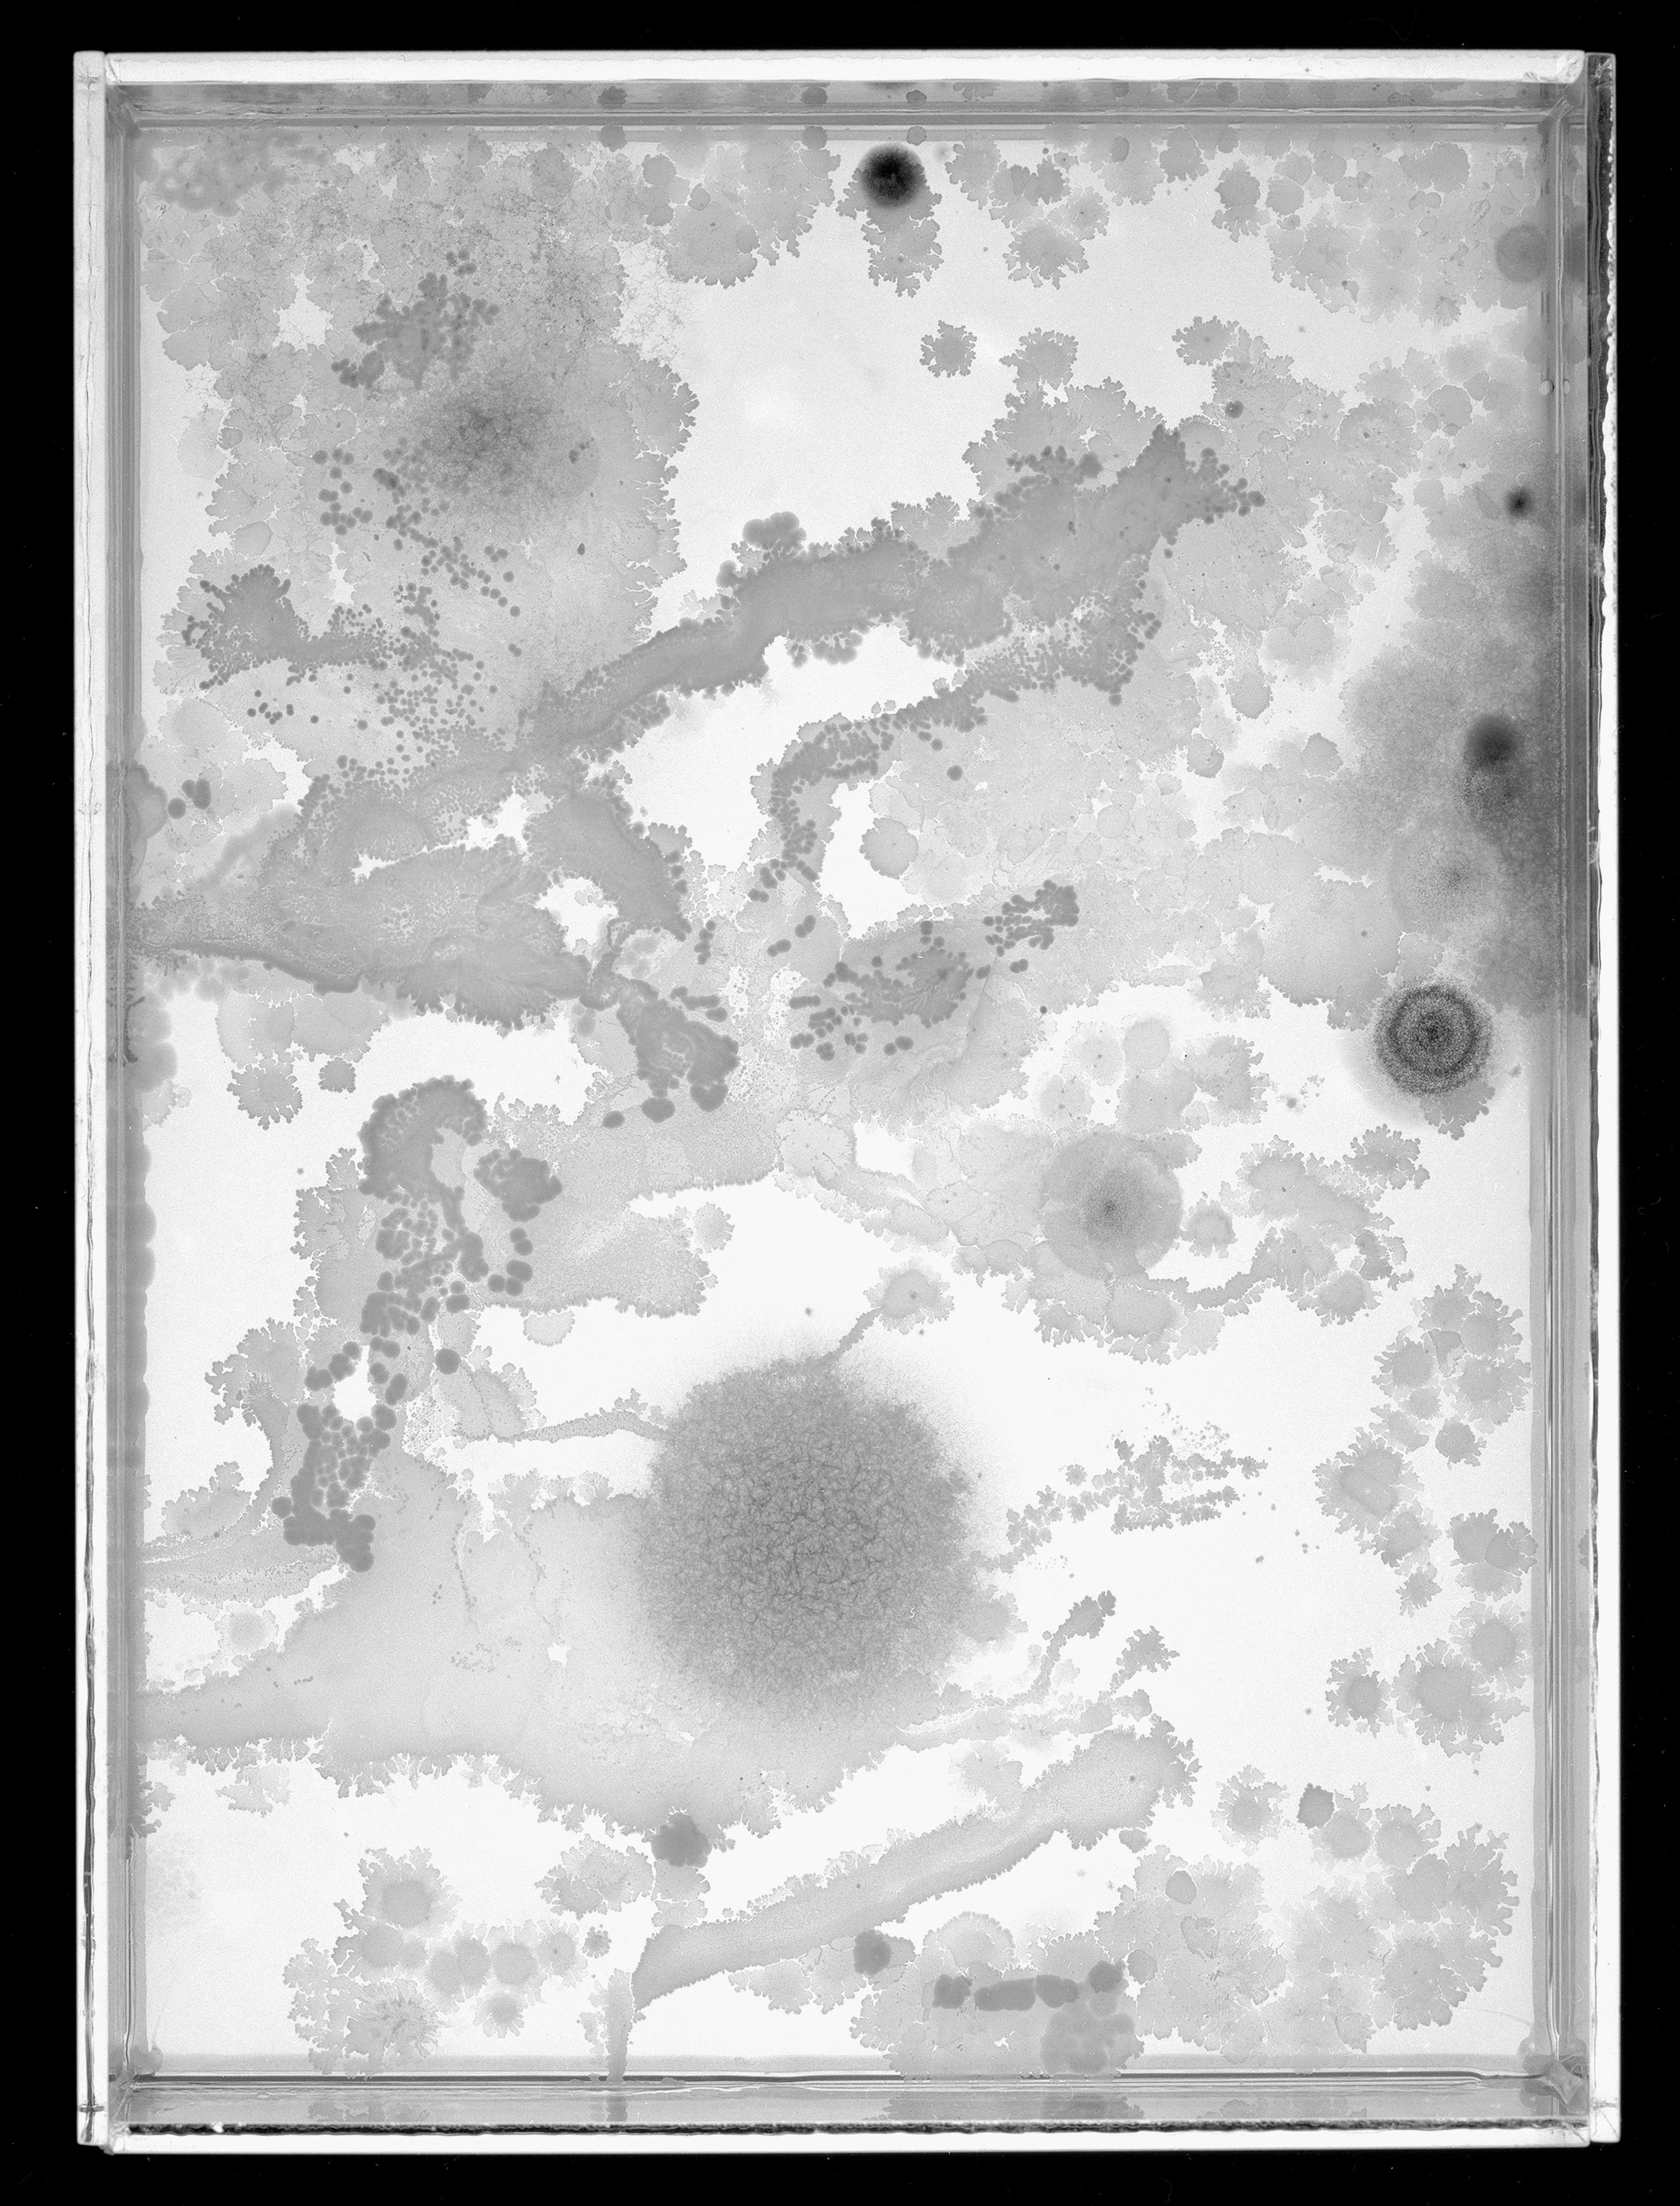
2023_Plates_13B_8x.jpg
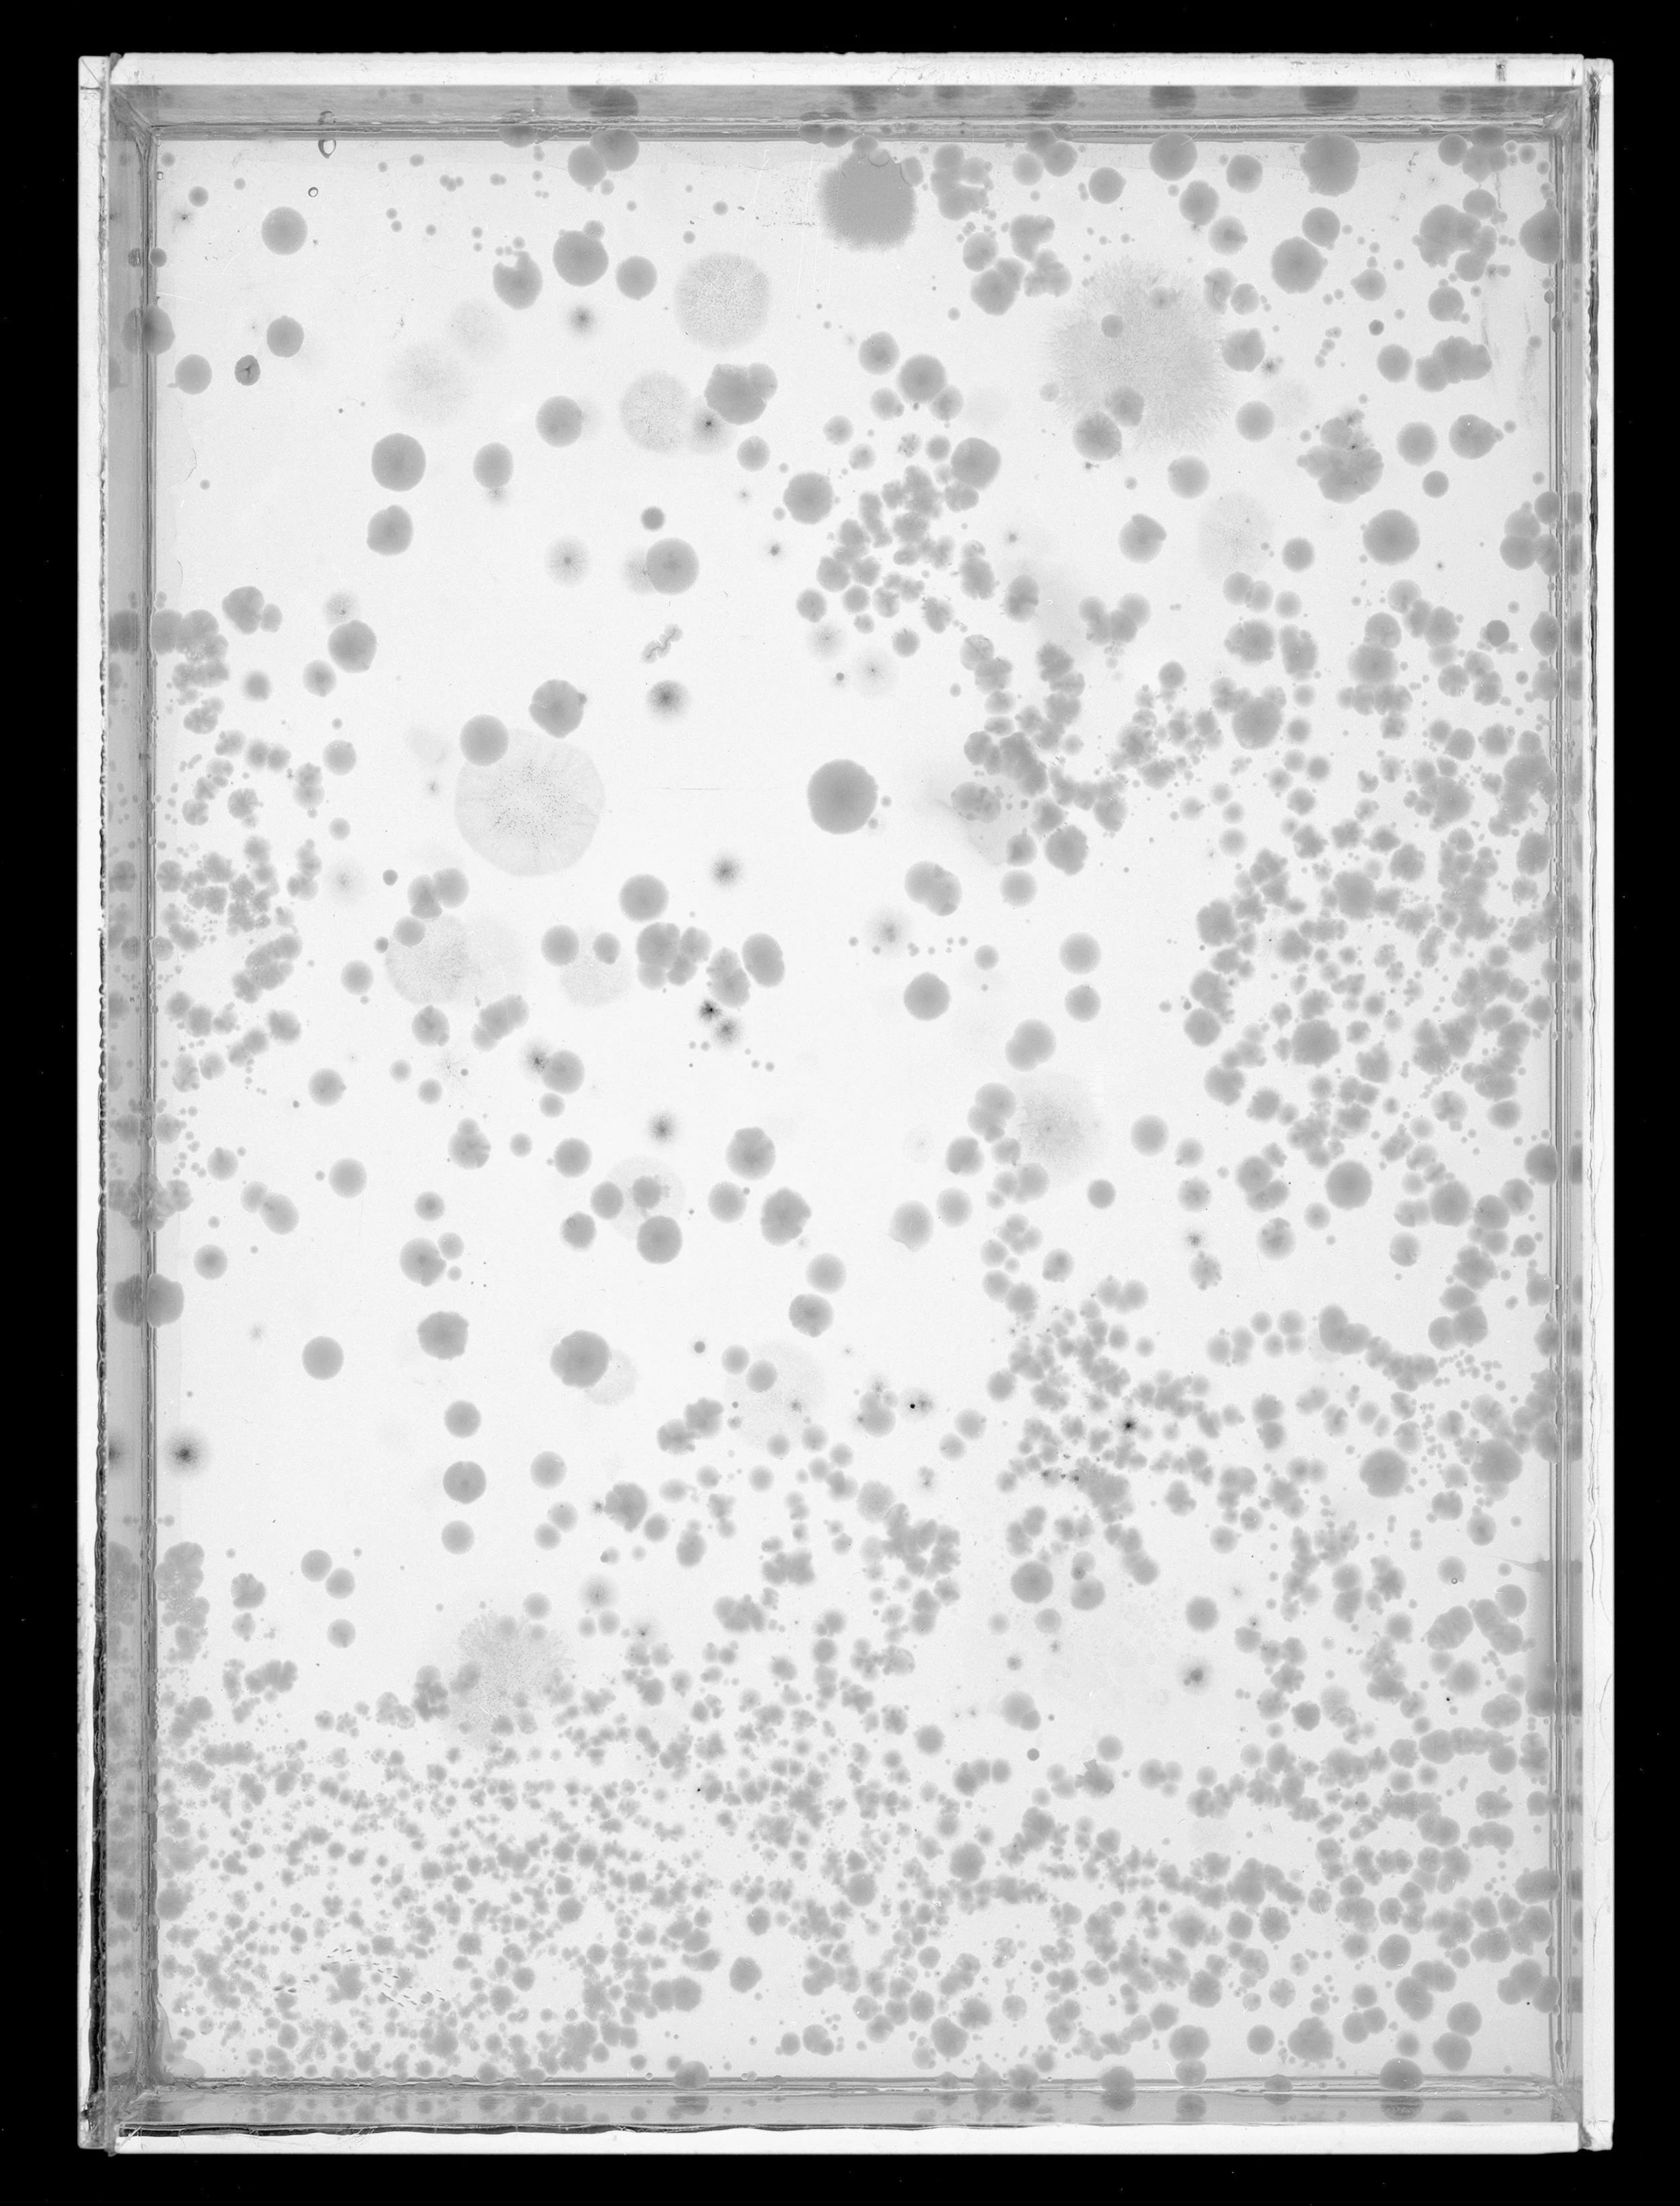
2023_Plates_15A_8x.jpg
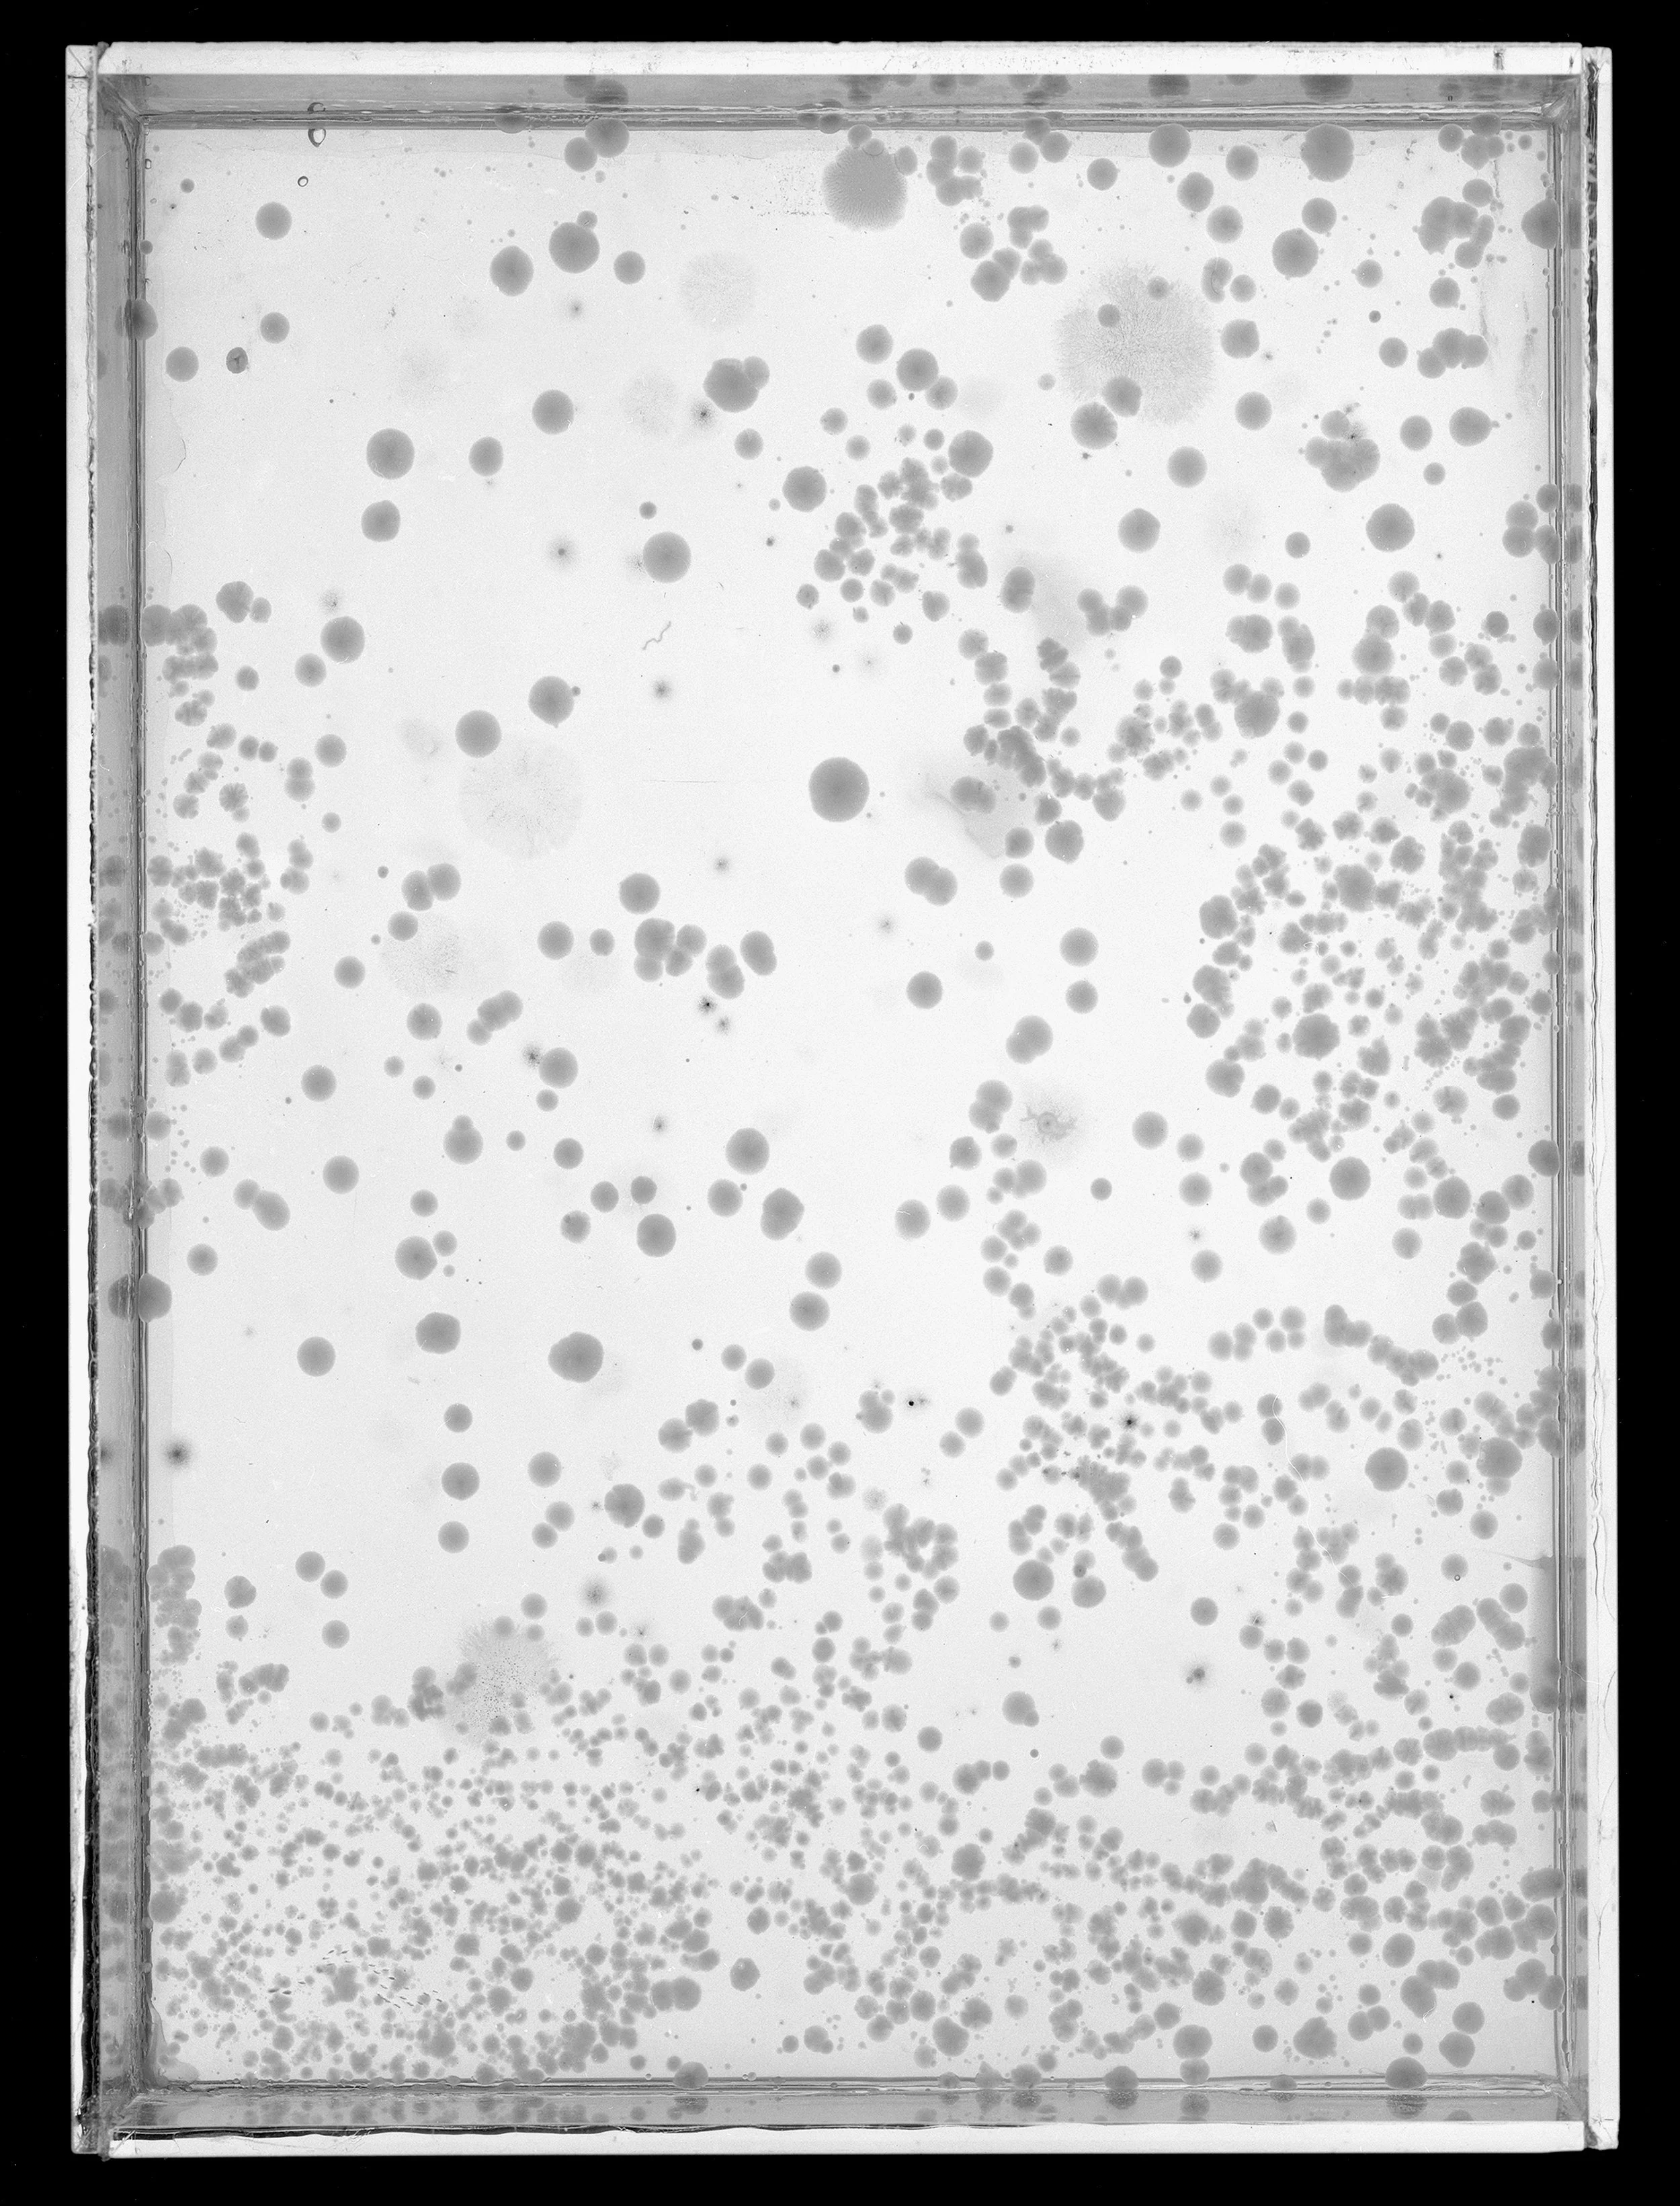
2023_Plates_15B_8.3.jpg

Wild Flies, 2022 to present
Gelatin silver prints, 16x20”
Wild green bottle and flesh flies (as opposed to “domestic” house flies) were temporarily captured and introduced to glass trays containing a layer of agar gelatin. The insects’ footprints were recorded on the gelatin as spots of pollen, bacteria and fungi, which subsequently grew over time into larger shapes.